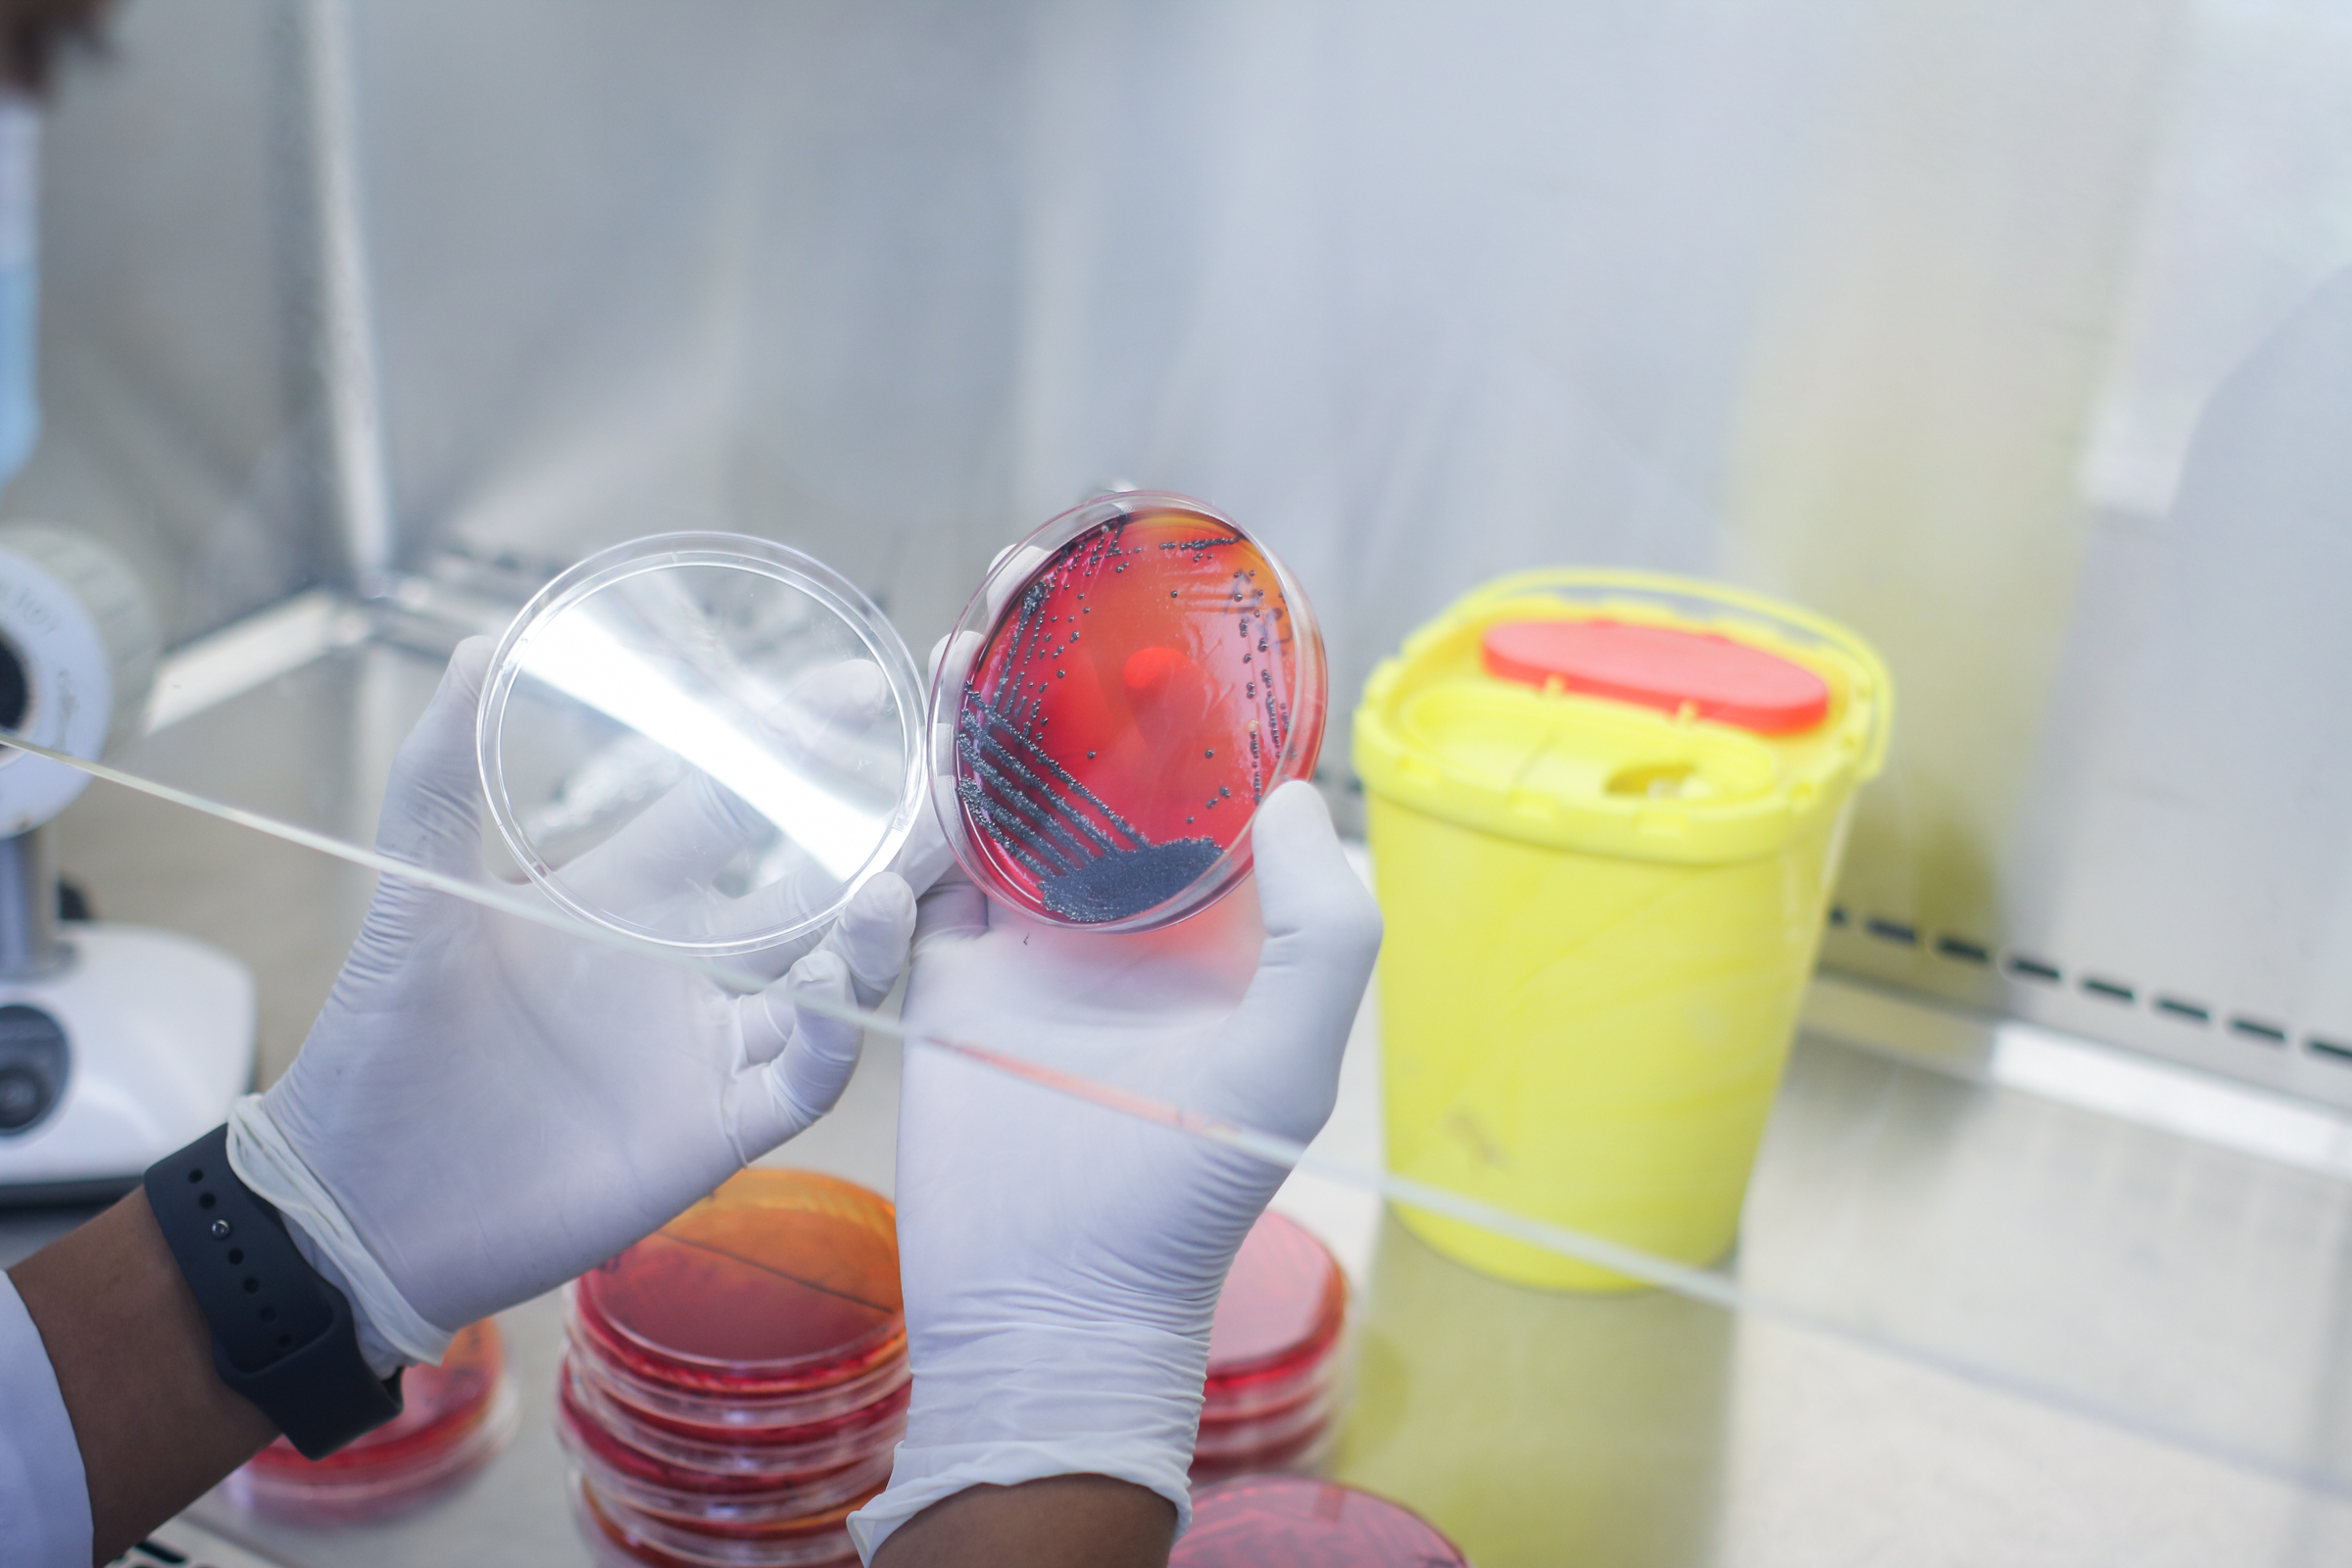
Slider Image:

ताजा जानकारी :

डा.बरुण कुमार शर्मा
प्रमुख पशु चिकित्सक

डा.रामचन्द्र सापकोटा
सूचना अधिकारी
परिचय
कृषि,वन तथा पर्यावरण मन्त्रालय अन्तर्गत पशु सेवा विभाग मातहतमा रहेको केन्द्रीय पशुपन्छी रोग अन्वेषण प्रयोगशाला (सीभीएल) नेपालमा पशु स्वास्थ्य सम्बन्धी रोग निदानको राष्ट्रिय रिफरल प्रयोगशालाको रुपमा रहेको छ। केन्द्रीय पशुपन्छी रोग अन्वेषण प्रयोगशालाले पशुपन्छीमा रोगहरूको पहिचानका लागि देशव्यापी परीक्षण सेवा प्रदान गर्छ। यसको मुख्य उद्देश्य रोगहरूलाई प्रारम्भिक चरणमै पत्ता लगाई यस्ता रोगको प्रकोप न्यूनीकरण सहित थप विस्तार हुन नदिनु हो। केन्द्रीय पशुपन्छी रोग अन्वेषण प्रयोगशालाले महामारी रोगको प्रकोपको अनुसन्धान, रोग अनुगमन तथा किसानहरूबाट प्राप्त नमूनाहरूमा विविध प्रयोगशाला परीक्षणहरू सञ्चालन गर्छ। यी परीक्षणहरू मुख्य रूपमा आर्थिक रूपमा महत्त्वपूर्ण तथा जनावरबाट मानिसमा सर्न सक्ने (जूनोटिक) रोगहरूमा केन्द्रित हुन्छन्। पशु स्वास्थ्यको राष्ट्रिय रिफरेन्स प्रयोगशालाका रूपमा केन्द्रीय पशुपन्छी रोग अन्वेषण प्रयोगशालाले आफ्नै कार्यविधि, परीक्षण प्रोटोकल र गुणस्तर मापदण्डहरू पालन गर्दै, निरन्तर नवीन प्रविधिहरू अपनाउँदै आएको छ। गुणस्तर प्रतिवद्धताको प्रमाणस्वरूप केन्द्रीय पशुपन्छी रोग अन्वेषण प्रयोगशाला राष्ट्रिय तथा अन्तर्राष्ट्र... थप पढ्नुहोस्